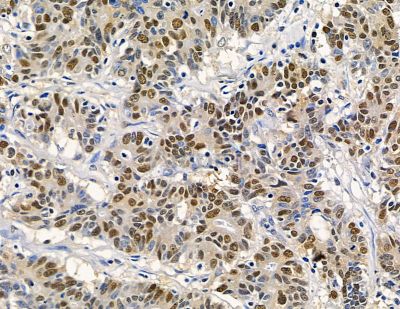
RFX2 Antibody - DF15783 at 1/100 staining human colorectal cancer by IHC-P.
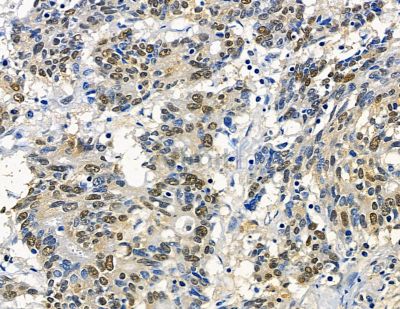
RFX2 Antibody - DF15783 at 1/100 staining human prostate cancer by IHC-P.

RFX2 Antibody - #DF15783
Related Downloads
Protocols
Product Info
*The optimal dilutions should be determined by the end user. For optimal experimental results, antibody reuse is not recommended.
*Tips:
WB: For western blot detection of denatured protein samples. IHC: For immunohistochemical detection of paraffin sections (IHC-p) or frozen sections (IHC-f) of tissue samples. IF/ICC: For immunofluorescence detection of cell samples. ELISA(peptide): For ELISA detection of antigenic peptide.
Fold/Unfold
DNA-binding protein RFX2; HLA class II regulatory factor RFX2; regulatory factor X 2 (influences HLA class II expression); Regulatory factor X 2; regulatory factor X2; RFX2; RFX2_HUMAN; trans acting regulatory factor 2;
Immunogens
A synthesized peptide derived from human RFX2.
- P48378 RFX2_HUMAN:
- Protein BLAST With
- NCBI/
- ExPASy/
- Uniprot
MQNSEGGADSPASVALRPSAAAPPVPASPQRVLVQAASSNPKGAQMQPISLPRVQQVPQQVQPVQHVYPAQVQYVEGGDAVYTNGAIRTAYTYNPEPQMYAPSSTASYFEAPGGAQVTVAASSPPAVPSHSMVGITMDVGGSPIVSSAGAYLIHGGMDSTRHSLAHTSRSSPATLEMAIENLQKSEGITSHKSGLLNSHLQWLLDNYETAEGVSLPRSSLYNHYLRHCQEHKLDPVNAASFGKLIRSVFMGLRTRRLGTRGNSKYHYYGIRLKPDSPLNRLQEDTQYMAMRQQPMHQKPRYRPAQKTDSLGDSGSHSGLHSTPEQTMAVQSQHHQQYIDVSHVFPEFPAPDLGSFLLQDGVTLHDVKALQLVYRRHCEATVDVVMNLQFHYIEKLWLSFWNSKASSSDGPTSLPASDEDPEGAVLPKDKLISLCQCDPILRWMRSCDHILYQALVEILIPDVLRPVPSTLTQAIRNFAKSLEGWLTNAMSDFPQQVIQTKVGVVSAFAQTLRRYTSLNHLAQAARAVLQNTSQINQMLSDLNRVDFANVQEQASWVCQCEESVVQRLEQDFKLTLQQQSSLDQWASWLDSVVTQVLKQHAGSPSFPKAARQFLLKWSFYSSMVIRDLTLRSAASFGSFHLIRLLYDEYMFYLVEHRVAEATGETPIAVMGEFNDLASLSLTLLDKDDMGDEQRGSEAGPDARSLGEPLVKRERSDPNHSLQGI
Research Backgrounds
Transcription factor that acts as a key regulator of spermatogenesis. Acts by regulating expression of genes required for the haploid phase during spermiogenesis, such as genes required for cilium assembly and function (By similarity). Recognizes and binds the X-box, a regulatory motif with DNA sequence 5'-GTNRCC(0-3N)RGYAAC-3' present on promoters. Probably activates transcription of the testis-specific histone gene HIST1H1T (By similarity).
Nucleus. Cytoplasm.
Note: Mainly expressed in the nucleus and at lower level in cytoplasm.
Belongs to the RFX family.
Restrictive clause
Affinity Biosciences tests all products strictly. Citations are provided as a resource for additional applications that have not been validated by Affinity Biosciences. Please choose the appropriate format for each application and consult Materials and Methods sections for additional details about the use of any product in these publications.
For Research Use Only.
Not for use in diagnostic or therapeutic procedures. Not for resale. Not for distribution without written consent. Affinity Biosciences will not be held responsible for patent infringement or other violations that may occur with the use of our products. Affinity Biosciences, Affinity Biosciences Logo and all other trademarks are the property of Affinity Biosciences LTD.